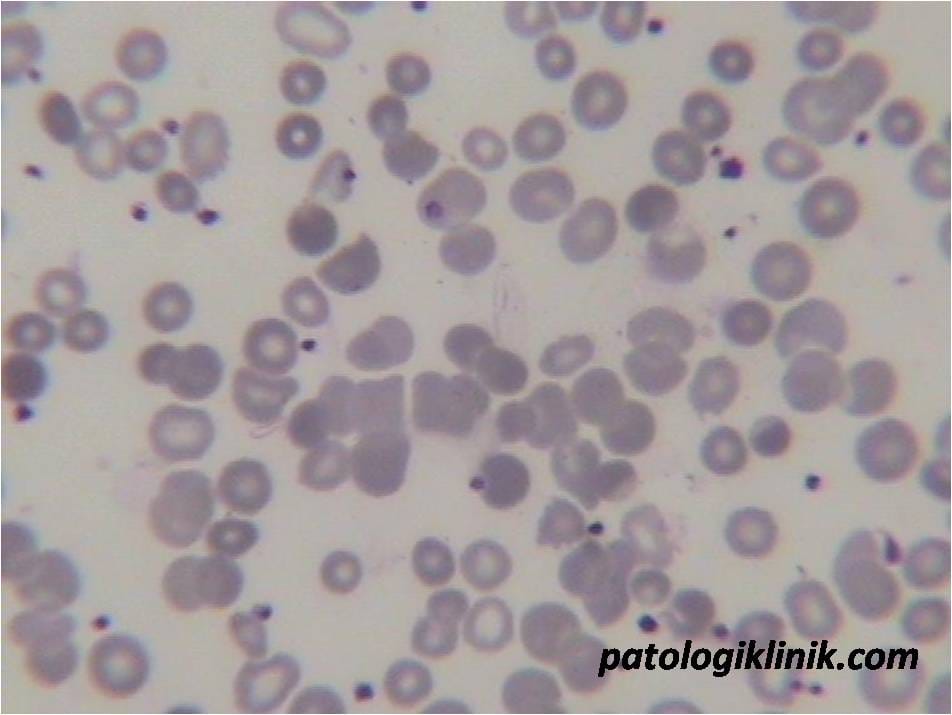
Gambaran Autoaglutinasi pada AIHA

Pengecatan Diff Quik, alternatif cepat dan mudah dari Wright
Sebagai tenaga kesehatan yang bekerja di laboratorium klinik, tentunya kita sudah terbiasa menggunakan cat Wright atau Giemsa sebagai cat utama dalam pengecatan apusan darah tepi. Lamanya proses mengecat atau hasil cat kotor sudah menjadi keluhan yang rutin kita keluhkan atau kita dengar dari teman-teman yang harus membaca apusan darah tepi.